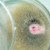
image

Centro de Conocimiento
El centro de conocimiento es el lugar adecuado para encontrar una amplia y variada información interesante. También le ofrece los conocimientos necesarios para apoyarle en las distintas áreas de su cultivo y sin preocupaciones. Haga clic en uno de los temas para ver la información disponible sobre el tema elegido.

Categorías
- Todos los artículos
- Limpieza, desinfección e higiene
- Plagas y enfermedades
- Agua
- Agentes de blanqueo para invernaderos
- Ganchos y rafia
- General Cambio de cultivo
- Clips
- Microelementos
- Categoría
- Plan de nutrición esquema
- Equipos de tratamiento
- Alambre
- Boquillas de pulverización
- Máquinas e instalaciones
- General Artículos de servicios
- General Protección del cultivo
- Fertilizantes
- Protección biológica del cultivo
- Protección química del cultivo
- Abejorros
- Noticias
- Categoría
- Novedades y promociones
- Pinzas y clips para injertos
- Opiniones de clientes
- Cuidado del cultivo
- Protección del cultivo
- Actualidad
- Cambio de cultivo
- Mecanización
-

Artículo ¿Qué es el manejo integrado de las plagas?
Los consumidores están cada vez más interesados en productos cultivados de forma orgánica. Aspectos como la sostenibilidad, el medio ambiente y la seguridad alimentaria juegan un papel importante en…
-

Artículo ¿Cómo asegurar un funcionamiento óptimo de los enemigos naturales?
Cada vez es más frecuente que los agricultores usen enemigos naturales. Para un óptimo funcionamiento de estos enemigos, hay tres factores importantes: el uso de buen material, controles de calidad y…
-

Artículo Cómo reconocer y combatir el virus del tomate (ToBRFV)
El ToBRFV es un virus fitopatógeno que pertenece a los Tobamovirus, donde también se incluyen el virus del mosaico verde moteado del pepino (CGMMV) y el virus del mosaico del tabaco (TMV). El virus…
-

Artículo Preguntas frecuentes sobre el virus rugoso del tomate (ToBRFV)
El ToBRFV está causando agitación entre los agricultores de todo el mundo. Es un virus muy persistente que puede permanecer oculto por un largo período de tiempo. Nuestra especialista en desinfección…
-

Artículo ¿Cómo sujetar el soporte de las trampas adhesivas?
El rollo de a trampa adhesiva se utiliza a menudo para identificar las plagas en los cultivos. Pero ponerlo en el lugar correcto parece ser una tarea difícil para mucha gente. Los soportes de la…
-

Artículo Consejos para mejorar la efectividad de Aphidoletes Aphidimyza en invierno
En invierno es más difícil conseguir buenos resultados con el mosquito Aphidoletes aphidimyza. Esto es debido al tiempo frío frecuentemente combinado con el comienzo de un nuevo cultivo. Teniendo en…
-

Artículo ¿Qué son las feromonas?
Las feromonas son químicos que los insectos y otros animales usan para comunicarse. Estas señales químicas tienen tres propósitos: atraer a las parejas, avisar a depredadores y encontrar comida. Con…
-

Artículo Control de calidad de enemigos naturales
Los enemigos naturales son organismos vivos, debido a ello son productos extremadamente vulnerables en la protección biológica de cultivos. Diferentes factores como temperatura y humedad tienen…
-

Artículo Tablas para convertir la cantidad de fertilizantes de microelementos de forma sólida a líquida
Los microelementos son los elementos más pequeños en la nutrición de las plantas, sin embargo juegan un papel importante en su crecimiento. Estos elementos son proporcionados a la planta a través de…
-

Artículo ¿Cuál es la diferencia entre sulfatos y quelatos?
Todos los cultivos necesitan nutrientes adecuados y suficientes para poder crecer bien. Las plantas necesitan mayor cantidad de algunos elementos nutritivos que de otros. Los elementos que la planta…
-

Artículo ¿Qué tipos de reguladores de crecimiento hay?
Los reguladores de crecimiento son productos que pueden influenciar el crecimiento de las plantas, por ejemplo el desarrollo de las raíces, los tallos, las hojas, los frutos y las semillas. Contienen…
-

Artículo Cómo limpiar goteros obstruidos
Los goteros son muy sensibles a la contaminación. La contaminación en los goteros causa diferencias de flujo de agua, lo que tiene un efecto negativo en la calidad de la cosecha. Por lo tanto, es…
-

Artículo ¿Cómo se llega a un sistema de riego libre de bacterias?
Reutilizar el agua de drenaje puede conllevar riesgos, los patógenos pueden acabar en el cultivo. Por ejemplo, al recircular el agua de riego en el cultivo de fresa, las bacterias Xanthomonas spp.…
-

Artículo ¿Cómo comprobar el valor del pH del agua?
Todo cultivo depende del agua. Si el agua es adecuada para ser administrada a un cultivo, depende del valor del pH del agua. El valor pH indica la acidez de una solución. Pero, ¿cómo comprobar el…
-

Artículo ¿Cómo se previene el daño como consecuencia del etileno?
El etileno (C2H4), es una hormona vegetal natural incolora e inodora que aparece tanto en el interior (en las plantas) como en el exterior (en el aire). Influye en el desarrollo y el crecimiento de…
-

Artículo ¿Cómo reconocer y combatir el Fusarium?
Fusarium oxysporum es un hongo de suelo que es común en los cultivos de invernadero. Casi todos los cultivos tienen un tipo de Fusarium específico, pero este hongo es un problema principalmente en…
-

Artículo Protocolo para lavarse las manos correctamente
Las enfermedades y las plagas pueden propagarse fácilmente a través de las manos para causar daños (extensos) a la cosecha. Para prevenir esto, es importante que se mantenga una buena higiene en los…
-

Artículo ¿Qué diferencias hay entre blanqueos y coberturas difusas?
Muchos cultivos necesitan “ayuda” en periodos soleados para crecer fuertes y sanos. Aunque la luz solar es esencial para los procesos en la planta, el exceso de luz solar en primavera y verano, puede…
-

Artículo ¿Cuál es la diferencia entre una bacteria y un virus?
Las bacterias y los virus son los patógenos más importantes en la horticultura y pueden causar grandes daños a los cultivos. A menudo se piensa que las bacterias y los virus son lo mismo, pero no es…
-

Artículo ¿Qué es un insecticida?
Un insecticida es un agente químico para la protección de cultivos que mata uno o más tipos de insectos, causando o repeliendo el daño en un cultivo. Los insecticidas tienen diferentes efectos, por…
-
Artículo ¿Qué es un fungicida?
Los hongos son la causa más importante de la pérdida de cosechas en todo el mundo. Un fungicida es un agente químico de protección de cultivos que controla las enfermedades fúngicas matando o…
-

Artículo Abejorros y pesticidas
Los pesticidas o productos químicos de protección de cultivos y los abejorros no siempre funcionan bien juntos. Los productos químicos pueden tener un efecto negativo en la población de abejorros o…
-

Artículo Cómo alimentar a los abejorros
Los abejorros comen polen. Obtienen la mayoría del polen que necesitan de las flores del cultivo, pero a veces esa cantidad no es suficiente. Una deficiencia de polen tiene una influencia negativa en…
-

Artículo ¿Cómo calibrar un medidor de conductividad?
Con nuestro medidor de conductividad puedes medir la concentración de la cantidad total de sales solubles en un líquido. Así, el medidor de conductividad es una importante herramienta para controlar…
-

Artículo ¿Cómo crear movimiento de aire en el invernadero?
Debido al buen aislamiento, los invernaderos modernos tienen poco aire natural. Esto hace que las temperaturas sean diferentes en diferentes áreas, por lo que se pueden crear zonas de aire fio o…
-

Artículo ¿Cómo elegir el macetero adecuado?
Cada cultivo tiene necesidades diferentes y el uso de la maceta adecuada puede contribuir a la calidad de su producto. Piensa en la elección del material adecuado, el tamaño correcto y los agujeros…
-

Artículo ¿Cómo reconocer y combatir la mosca blanca?
La mosca blanca es una plaga común en la horticultura, tanto en cultivos hortícolas como en ornamentales. El insecto daña las plantas absorbiendo la savia. Esto produce el debilitamiento de la…
-

Artículo 10 consejos para el mantenimiento de maquinaria
Una máquina con un buen mantenimiento es más segura de usar. Además, manteniendo adecuadamente las máquinas y revisándolas regularmente, puede prevenir altas facturas de reparación inesperadas. Por…
-

Artículo ¿Cómo reconocer y combatir la Botrytis?
La Botrytis es un hongo y es la mayor causa de daños en la horticultura. Este hongo también se conoce como Botrytis cinerea, podredumbre gris, moho gris, hongo del moho o enfermedad de la planta del…
-

Artículo ¿Cómo puedes luchar contra el virus del mosaico verde moteado del pepino?
El virus del mosaico verde moteado del pepino (CGMMV) es una enfermedad vegetal que se produce en el cultivo del pepino y es especialmente visible en las hojas jóvenes. El virus se propaga de…
Pagination
Contact
Fiable, profesional y rápido
Rellene el formulario y nos pondremos en contacto con usted en 24 horas. Nuestro equipo estará encantado de atenderle.
- Más de 130 años de experiencia
- Consejos de expertos



























